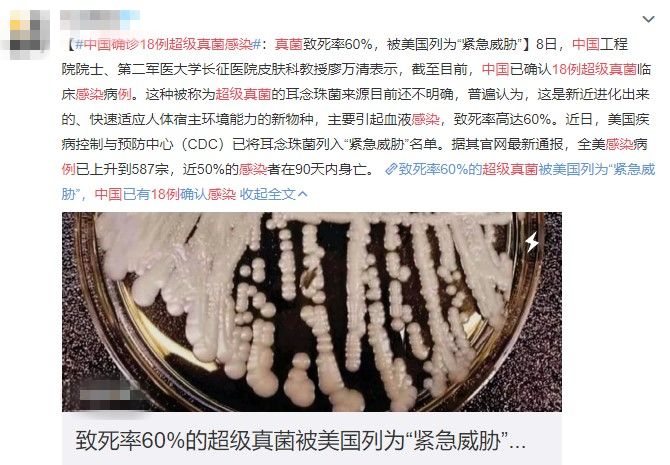
真菌感染死亡率最高的疾病,致命真菌怎么预防

点击“重庆药品监管” 可以订阅哦!
这几天,#中国确诊18例超级真菌感染#在微博、朋友圈引起了一阵恐慌,因为据报道这种超级真菌致死率高达60%,而且已经在美国多地爆发。
图片来源:微博截图
据《纽约时报》4月6日报道,去年5月纽约一名老年男子做腹部手术时,被发现感染了这种超级真菌,住院90天后死亡。
但这种致命的真菌却顽强地存活下来,病房很多地方都遭到了入侵。

截至2019年2月28日,全美耳念珠菌感染临床病例统计地图 图片来源:美国CDC官网
目前,这种名为“耳念珠菌”的多重耐药真菌在纽约、新泽西和伊利诺伊等12个州流行。引起全美587例感染,死亡率达30%-60%,近50%以上的感染者在90天内身亡。
这种“超级真菌”已被美国疾病预防控制中心列为“紧急威胁”名单。

图片来源:网络
在我国,截至2019年4月8日,已经确认了18例超级真菌感染病例,但目前没有出现美国那样的爆发流行感染。
培养皿中的耳念珠菌菌株 图片来源:美国CDC官网
我们会不会被超级真菌感染呢?哪些人又容易被盯上?今天我们就来系统了解一下这个神秘的超级真菌。
什么是“超级真菌”?
这里所说的“超级真菌”实际上是一种被称为“耳念珠菌”(Candida auris)的真菌,是一种出芽酵母。
最早于2009年从一名日本患者和15名韩国患者的外耳引流液中分离得到,可引起严重的念珠菌感染,对目前的抗真菌药物有抗性。

图片来源:网络
耳念珠菌的脚步遍及全球,迄今为止已经在全球造成了数次院内爆发性感染。
“超级真菌”对人有哪些威胁?
临床上通常认为耳念珠菌可以引起真菌血症、脑室炎、骨髓炎、恶性中耳炎(含耳乳突炎)、严重腹腔感染、心包炎、严重胸腔积水、外阴道炎等。
最初的症状是发烧、疼痛和疲劳,如果真菌扩散到血液、大脑或心脏,则会夺人性命。

图片来源:网络
然而,耳念珠菌感染与其他念珠菌感染不同的是,还不确定其与呼吸系统、泌尿系统和软组织感染有直接相关。
什么样的人群容易被“超级真菌”感染?
ICU入住患者、手术病人和糖尿病患者等都是容易感染耳念珠菌的人群。

此外,患者的健康状态,如免疫系统是否受到抑制、是否有严重的并发症、是否有中枢静脉插管或导尿管、是否进行非肠道营养以及长期使用广谱抗菌药物等因素都可能成为引起感染的危险因素。
但免疫力正常的人群感染超级真菌的风险并不大,所以无需恐慌 !
“超级真菌”为什么令人生畏?
耳念珠菌不容易通过常规的实验室诊断发现,一般通过质谱技术和生物技术手段来判断,因此诊断效率较低。

耳念珠菌是一种来自黑色咸水湖的生物,可能是一种新进化出来的病原体,临床使用的三大类抗真菌药物都不能将其完全杀灭。
耳念珠菌对于目前最广泛使用的抗真菌药物氟康唑基本上都具有抗性,而棘白菌素类药物中的阿尼芬净、卡泊芬净、米卡芬净对其活性最强,但只能作为一种经验式治疗方案,两性霉素B只用于棘白菌素无效时的尝试性治疗。

此外,超级真菌生命力极强,以一种具有高度抵抗力的“生物膜”的形式长时间存活于医务人员皮肤、医院设施表面以及环境中。
虽然10%聚维酮碘用于术前擦洗,对于早期以及成熟的耳念珠菌生物膜均有破坏作用。但是常规的环境、器具消毒剂如双氧水和常规浓度的双氯苯双胍己烷等都不易将其杀死。
因此,容易在环境、人体皮肤乃至治疗器械中传播,造成院内爆发性感染。
如何防控“超级真菌”感染
1
发现感染者应该第一时间严格隔离
2
注意手部消毒
3
对环境和设备用推荐的消毒剂进行消毒
4
感染者转院时应该提前告知转入医院
5
对与感染者密切接触的人群进行排查
6
监测新发病例,探明传播途径,加以阻隔
因此,对于超级真菌无需过度恐慌,但要注意的是保持健康生活习惯,不滥用抗生素。

END
▼
往期精彩回顾
▼
家里这些“隐形毒药”,会让孩子变呆变傻!长期吃止痛药会上瘾?真相是……最怕突如其来地抽筋,学8个动作快速缓解
文章转载自“科普中国”(ID:Science-China)
作者:田靖